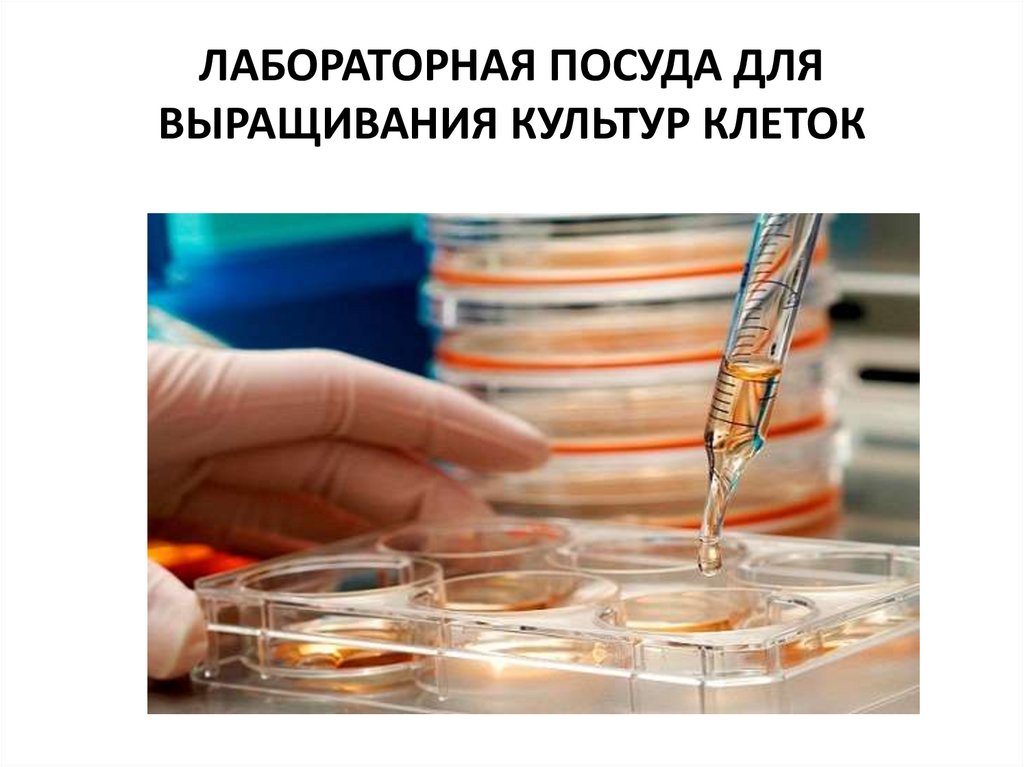

Similar presentations:
Вирусы. Открытие вирусов
1.
ВИРУСЫ2.
3.
4.
ОТКРЫТИЕ ВИРУСОВ• 12 февраля 1892 г – официальная дата
рождения новой науки –ВИРУСОЛОГИИ
• вирус от лат. Virus - яд
5.
6.
ИЗ ИСТОРИИ ВИРУСОВ• 1500 г до н. э. – Египетские мумии с
деформацией костей ног, характерных для
больных полиомиелитом
• 430 г до н. э. – Первое упоминание об
эпидемии гриппа в Афинах
• 1200 г – Иракский манускрипт,
описывающий возможность передачи
вируса бешенства от собаки к укушенному
человеку
7.
ОСНОВНЫЕ СВОЙСТВА ВИРУСОВНе имеют клеточного строения
Ультрамикроскопические размеры (20-350 нм)
Содержат один тип нуклеиновой кислоты (или ДНК, или РНК)
Не способны к росту и бинарному делению
Размножаются путём воспроизведения себя из собственной
геномной НК
• У вирусов отсутствуют собственные системы мобилизации
энергии
• У вирусов нет собственных белоксинтезирующих систем
• Являются облигатными внутриклеточными паразитами
8.
Форма и величинавирионов некоторых
вирусов
9.
• Вирусы существуют в 2-х качественно разных формах:внеклеточной – вирион и внутриклеточной - вирус
10.
СТРУКТУРА ВИРИОНА• Различают простые и сложные
• У простых - НК связана с белковой оболочкой
– капсидом, называется нуклеокапсид
• У сложных - капсид окружён оболочкой суперкапсидом
11.
12.
МОРФОЛОГИЯ ВИРИОНОВ• Палочковидные
• Пулевидные
• Сферические
• Нитевидные
• В виде сперматозоида
13.
КапсидСостоит только из белка
Не является цельной структурой,
состоит из капсомеров
• Функции:
1. Защитная
2. Связывание с рецепторами клеткимишени
3. Обусловливают антигенные и
иммуногенные свойства вирионов
14.
Типы симметрии капсидаСпиральный –
• капсомеры, выстраиваются по
ходу спирали НК
• лучше защищает геном
• требует большое количество
белка
• при отсутствии суперкапсида
придает вирусу палочковидную
или нитевидную формы
15.
Кубический тип симметрии• Капсид состоит из сочетания равностороннихтетраэдров, октаэдров и других
многоугольников
• Внутри образуется пространство, в котором
помещается НК
• При отсутствии суперкапсида придает форму
сферы или икосаэдра
16.
Бинарная симметрия –у бактериофагов головка имеет кубический ,
а отросток спиральный тип симметрии
17.
18.
Суперкапсид1.
2.
3.
Имеется не у всех вирусов, расположен поверх
капсида
Характерен для сложноорганизованных вирусов
(вирус ВИЧ, гриппа, герпеса)
Возникает во время выхода вируса из клеткихозяина
Представляет модифицированный участок ядерной
или наружной цитоплазматической мембраны
клетки-хозяина
Состоит из гликопротеидов и липопротеидов
Функции:
защитная
распознает клеточные рецепторы
обеспечивает проникновение вируса путем
слияния с ЦПМ клетки
19.
ХИМИЧЕСКИЙ СОСТАВВИРИОНОВ
• Простые состоят из НК и белков
• Сложные состоят из НК, белков, липидов
и углеводов
20.
НУКЛЕИНОВЫЕ КИСЛОТЫВИРИОНОВ
• Вирусные ДНК:
двунитевые или однонитевые,
линейные или кольцевые
• Вирусные РНК:
однонитевые или двунитевые,
фрагментированные или цельные,
линейные или кольцевые
• Различают:
«+»РНК, выполняющие функции генома и и-РНК,
«-»РНК, выполняющие только геномную функцию
21.
ВИРУСНЫЕ БЕЛКИ• Структурные:
капсидные,
внутренние,
матриксные,
суперкапсидные
• Неструктурные:
вирусиндуцированные ферменты,
регуляторные белки,
нестабильные белки – предшественники,
ферменты
22.
Ферменты вирусовФерменты, необходимые
для проникновения
вируса в клетку:
Лизоцим у бактерифагов
АТФ-азы (вирусы герпеса)
Нейраминидаза (вирусы гриппа,
парагриппа, паротита)
Ферменты репродукции:
(в основном заимствуются
у клетки-мишени)
Обратная транскриптаза
(ВИЧ)
23.
ЛИПИДЫ И УГЛЕВОДЫ ВИРИОНОВ• Имеют клеточное происхождение
• Основной компонент суперкапсида
• Липиды способствуют стабильности вириона
24.
Вирусные геномы(примеры)
• Однонитевая нефрагментированная
линейная «+»РНК (в. полиомиелита)
• Однонитевая фрагментированная линейная
«-»РНК (в. гриппа)
• Однонитевая линейная «+»РНК –
диплоидный набор (ВИЧ)
• Двунитевая линейная ДНК (в. герпеса)
25.
ТАКСОНОМИЯ И КЛАССИФИКАЦИЯ ВИРУСОВ• Царство Vira
• 2 подцарства: рибовирусы и
дезоксирибовирусы
• Порядок – имеет окончание –virales
• Семейство имеет окончание –viridae
• Род имеет окончание -virus
26.
Систематика вируса гриппа• Царство – Vira
• Подцарство - Рибовирусы
• Порядок - Mononegavirales
• Семейство – Orthomyxoviridae
• Род – Influenzavirus
• Вирус гриппа типа А, В, С
27.
28.
29.
РЕПРОДУКЦИЯ ВИРУСОВ1. Адсорбция вирионов
АДСОРБЦИЯ вирионов на клетке связана с
тропизмом вирусов – избирательным
поражением клеток определённых тканей и
органов у определённых видов организмов
30.
2. Проникновение вирионов в клетку2 способа:
- путём эндоцитоза (виропексиса)
(простые и сложные вирусы)
- путём слияния суперкапсидной оболочки
вируса с клеточной мембраной
31.
3. Депротеинизация вирусов2 способа
1. у вирусов, проникших путём эндоцитоза –
под действием лизосомальных ферментов
2. у вирусов, проникших путём слияния – с
помощью ферментов клеточной мембраны
32.
4. Экспрессия вирусного геномаСинтез компонентов вириона начинается с:
1. транскрипции - образования на матрице геномной НК
комплементарных и-РНК,
2. затем трансляция - информация переводится на
специфическую последовательность аминокислот.
3. Репликация - на матрице исходной геномной НК
синтезируется множество копий – будущих вирусных
геномов.
У вирусов с различным типом генома репликация
происходит по-разному и осуществляется вирусными
или клеточными полимеразами
33.
5. Морфогенез – формирование вирионов• Простые вирусы – путём самосборки
• Сложные вирусы – в несколько этапов:
- образуется нуклеокапсид
- нуклеокапсид взаимодействует с
мембранами клетки и «одевается»
суперкапсидной оболочкой
- у некоторых под суперкапсидом
формируется матриксный слой (М-слой)
34.
6. Выход вирионов из клетки2 способа
1 – «взрывной» путь (простые вирусы)
2 – путём почкования, почкуясь через мембраны клетки,
вирусы приобретают суперкапсид (сложные вирусы)
35.
АБОРТИВНЫЙ ТИП ВЗАИМОДЕЙСТВИЯВИРУСОВ С КЛЕТКОЙ
•Причины возникновения абортивного типа
взаимодействия вируса с клеткой:
1. Заражение чувствительных клеток
дефектными вирусами (напр., в. гепатита D)
или дефектными вирионами
2. Заражение стандартным вирусом
генетически резистентных к нему клеток
3. Заражение стандартным вирусом
чувствительных клеток в неразрешающих
условиях
4. Апоптоз
36.
ИНТЕГРАТИВНЫЙ ТИП (ВИРОГЕНИЯ)• Взаимное сосуществование вируса и клетки в
результате интеграции (встраивания) НК вируса в
хромосому клетки хозяина
• Вирогения характерна для умеренных ДНКсодержащих бактериофагов, онкогенных вирусов,
ВИЧ
• Провирус – встроенная в хромосому клетки ДНК
вируса, генетическая информация провируса может
быть причиной онкогенной трансформации клеток и
развития опухолей, развития аутоиммунных и
хронических заболеваний
37.
КУЛЬТИВИРОВАНИЕ ВИРУСОВ38.
ЛАБОРАТОРНЫЕ ЖИВОТНЫЕИспользование животных ограничено из-за:
- невосприимчивости животных ко многим
вирусам человека
- контаминации животных посторонними
микробами
- экономических и этических соображений
39.
ЭМБРИОНЫ ПТИЦ• ДОСТОИНСТВА МОДЕЛИ - возможность накопления вирусов в больших количествах
- отсутствие скрытых вирусных инфекций
- доступность для любой лаборатории
• НЕДОСТАТОК –
- многие вирусы не размножаются в эмбрионах птиц
40.
41.
42.
КУЛЬТУРЫ КЛЕТОК (ТКАНЕЙ)• Дж. Эндерс и соавторы разработали метод
культур клеток в 50-е гг. ХХ в. и получили
Нобелевскую премию
• Клетки, полученные из различных органов и
тканей размножают вне организма на
искусственных питательных средах в
специальной лабораторной посуде
43.
44.
ЛАБОРАТОРНАЯ ПОСУДА ДЛЯВЫРАЩИВАНИЯ КУЛЬТУР КЛЕТОК
45.
ЛАБОРАТОРНАЯ ПОСУДА ДЛЯВЫРАЩИВАНИЯ КУЛЬТУР КЛЕТОК

biology
biology








